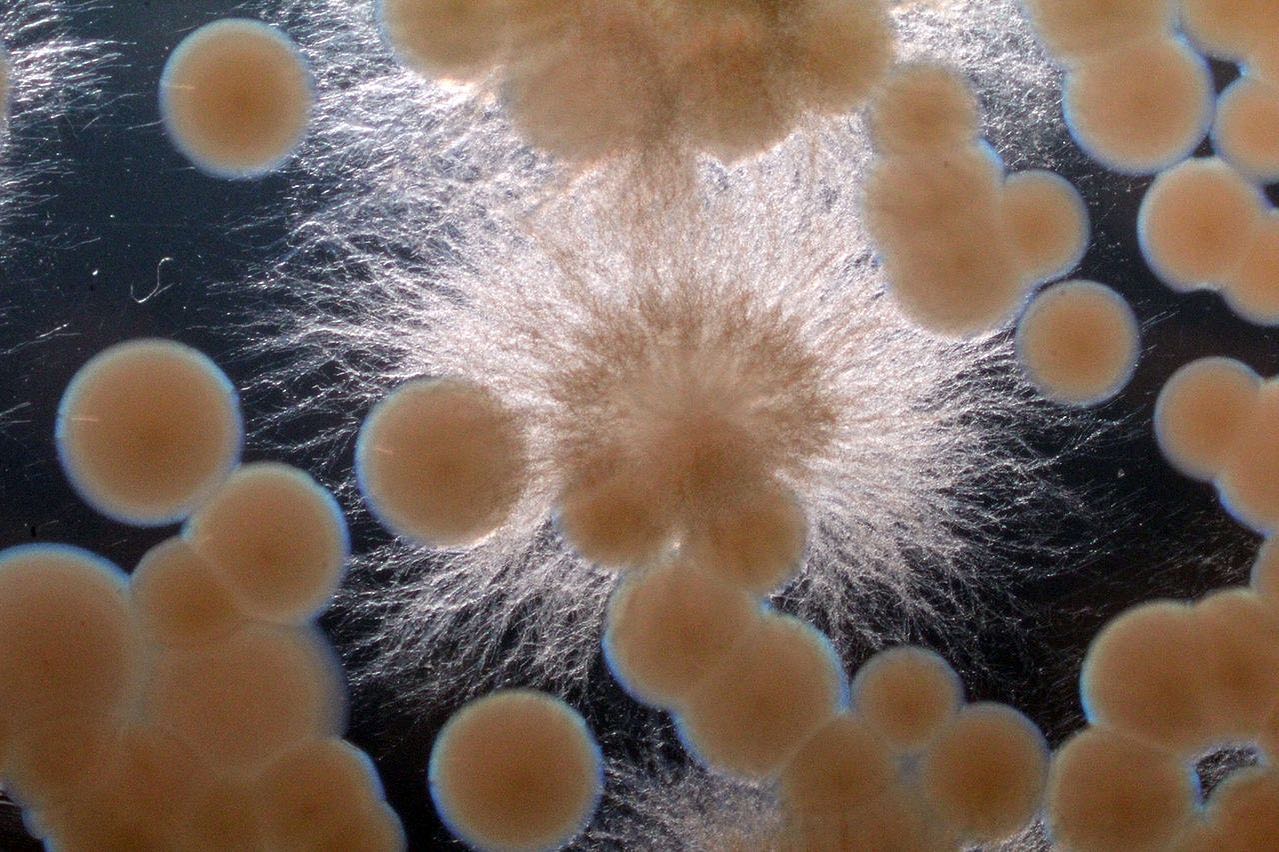

У рамках співпраці Migros оцінюватиме сприйняття споживачами нових альтернатив тунця та сига, а також їх потенціал зробити революцію на ринку морепродуктів у Європі.
Aqua Cultured Foods представила перший у світі аналог цільних морепродуктів, розроблений за допомогою мікробної ферментації, на початку цього року.
Технологічна компанія «вирощує» свої альтернативи за допомогою технології бродіння, яка дозволяє створювати реалістичне філе.
Завдяки цьому її продукти виділяються серед інших альтернатив риби та морепродуктів, що є на ринку. Останні, як правило, випускаються у вигляді подрібненого тунця або шматочків у паніровці.
Інвестори зацікавлені в тому, щоб Aqua заповнила «білий простір» в категорії цільних морепродуктів. Нещодавно вони вклали в стартап понад $2 млн посівного фінансування.
На сьогодні це є одним із найбільших раундів у сфері біоферментації

Першими продуктами, які Aqua планує вивести на ринок, є філе тунця та сига високої якості для суші, а також альтернативи креветкам і кальмарам.
«Ми готові познайомити швейцарський ринок з майбутнім альтернативних білків», – сказав Деніел Кох, старший менеджер проєкту від Migros
До речі, партнерство Aqua Cultured Foods з Migros зародилось зі швейцарського інкубатора Kickstart 2021.
Саме після участі в ньому стартап отримав шанс попрацювати з великими європейськими харчовими рітейл-компаніями, такими як Migros і Coop.
Джерела: FoodIngredientsFirst, Aqua Cultured Foods

